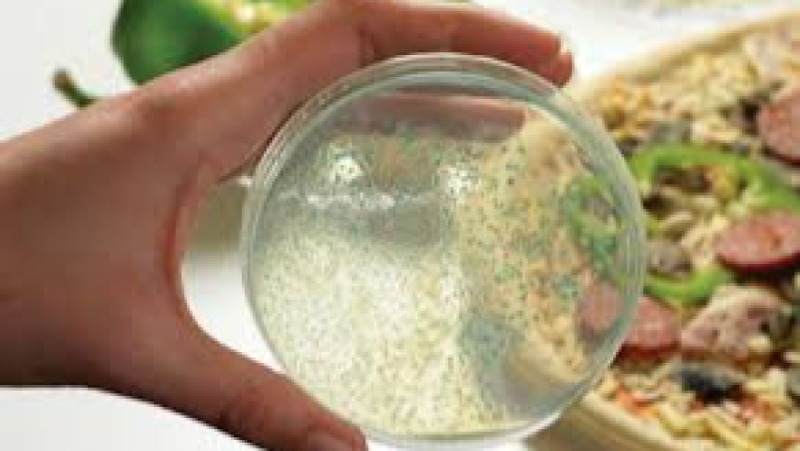
Microbiological Criteria and Predictive Modeling in Food Training Course

Advance your Lab testing expertise with 2 curated programs covering applied methodologies, analytics, and automation.
Certified Courses
Duration Range
Practical Focus
Delivery Modes
Build a competitive edge with structured learning paths and real implementation support tailored to Lab testing adoption.
Develop job-ready Lab testing capabilities using real datasets and guided assignments.
Align Lab testing proficiency with organizational goals and measurable performance improvements.
Train with industry specialists delivering personalized feedback and implementation support.
Explore instructor-led and hybrid programs aligned to practical Lab testing use cases across industries.
Showing 1-2 of 2 courses

Culinary Science for Food Scientists Training Course is designed to equip food scientists with advanced culinary knowledge, food technology expertise, and sensory evaluation skills necessary for driving food innovation and product development in the global marketplace.
Culinary Science for Food Scientists Training Course is designed to equip food scientists with advanced culinary knowledge, food technology expertise, and sensory evaluation skills necessary for driving food innovation and product development in the global marketplace.
Microbiological Criteria and Predictive Modeling in Food Training Course is designed to equip participants with essential knowledge and practical expertise in modern food safety management.
Microbiological Criteria and Predictive Modeling in Food Training Course is designed to equip participants with essential knowledge and practical expertise in modern food safety management.
Expand your learning path with complementary software capabilities.
1+ specialized courses ready to deliver.
1+ specialized courses ready to deliver.
3+ specialized courses ready to deliver.
1+ specialized courses ready to deliver.
1+ specialized courses ready to deliver.
1+ specialized courses ready to deliver.
Partner with Datastat Training Institute for immersive Lab testing programs delivered by certified practitioners with global project experience.